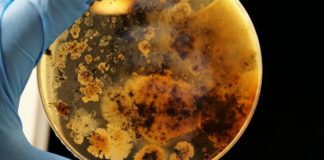
Et si c’était dans notre système digestif que résidait la jeunesse éternelle ? Le-secret-de-la-jeunesse-eternelle-reside-t-il-dans-notre-systeme-digestif

C’est ce qu’affirme une nouvelle étude menée par des chercheurs de l’université catholique de Louvain, en Belgique. Ils viennent d’établir un lien statistique entre la présence de certaines bactéries intestinales et la dépression. Certaines bactéries concourent à produire des dérivés de la dopamine (hormone du bien-être) et sont associées à une meilleure qualité de vie, d’autres pas.
Deux familles de bactéries, influençant la dépression, ont particulièrement retenu l’attention des chercheurs : Coprococcus et Dialister. Elles étaient systématiquement retrouvées dans le microbiote (ou flore intestinale) de personnes souffrant de dépression, indépendamment du traitement antidépresseur. Les résultats ont été validés dans un essai portant sur 1 063 personnes néerlandaises et plusieurs centaines de patients cliniquement déprimés aux hôpitaux universitaires de Louvain, en Belgique. Mais, pour d’autres experts, la dépression ne serait pas liée à la présence prépondérante de telle ou telle bactérie, mais plutôt à un déséquilibre général de la flore intestinale.